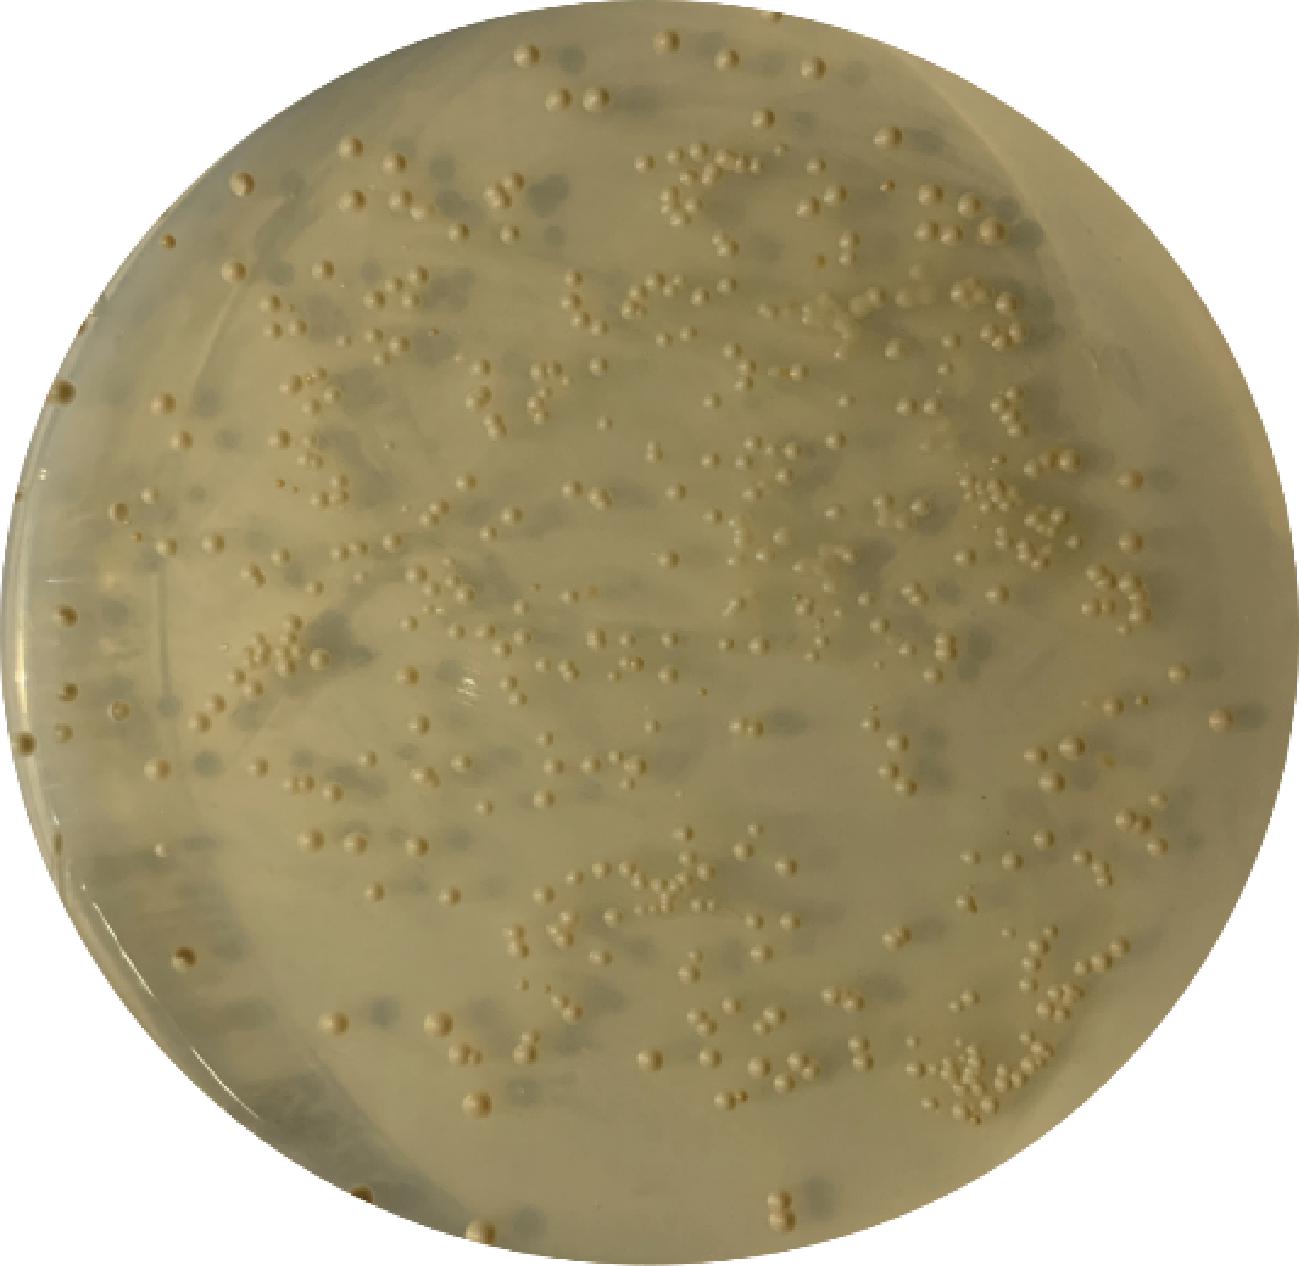

随着高毒有机氯和有机磷农药被禁用,具有高效、低毒、广谱等特点的拟除虫菊酯类农药(pyrethroids pesticides,PYRs)在农业生产中得到了广泛的应用[1-2]。由于PYRs具有迁移性和蓄积性,其在农产品中频繁检出并伴随部分超标[3-4],已对食品安全和人类身体健康构成威胁。目前在国内外农产品中检出的10多种PYRs中,氯氰菊酯(cypermethrin,CY)检出率最高,也是PYRs常用种类和代表。张贤辉等[5]对市售叶类蔬菜进行随机抽检(421份),检测到7种PYRs,其中氯氰菊酯和联苯菊酯含量均超过GB 2763—2021《食品安全国家标准 食品中农药最大残留限量》规定的最大残留限量。陈湘艺等[6]调查发现草鱼的内脏和鳃中都含有甲氰菊酯,并且内脏中的残留浓度是鳃中的22.7倍。
由酯酶催化的酯键断裂是PYRs解毒的关键步骤[7],因此微生物酶被视为降解农药残留的绿色技术。现已从微生物、昆虫、动植物中发现了不同的PYRs酯酶[8],且部分具有PYRs降解作用的酯酶被纯化和表征[9-12],但大多数研究集中在酶学性质上,对酶的降解效果及应用的探究十分有限。目前大多数PYRs降解酯酶的最适反应温度为35~80 ℃,低温下催化效率较低,尤其是清洗果蔬表面残留的PYRs时,中高温酶存在较大局限性。FAN等[13]在毛豆腐宏基因组中得到最适温度为18 ℃的酯酶Est684,但目前关于PYRs适冷酯酶及其机制的研究极少,而本课题组前期获得枯草芽孢杆菌J6源适冷酯酶Est13[14],在降解农产品农药残留领域具有较大的研究潜力。
一些研究表明,酯酶基因通常选择在大肠杆菌中进行纯化和表征,并且有较高水平表达[10,15-16],但细菌分泌酯酶的应用具有一定局限性[17]。随着酵母转化系统的建立和重组DNA技术的发展,在某些重大课题的研究中,酵母已取代大肠杆菌成为重要的外源基因表达系统之一[18]。为了能最大限度地应用于食品工业或产物用于食品工业[19],需要选择食品级表达系统[20],酿酒酵母则是十分理想的选择,但目前未见有氯氰菊酯降解酯酶基因在酿酒酵母中表达的报道。
本课题组前期对酯酶est13基因在大肠杆菌E.coli BL21(DE3)中进行了成功表达及降解验证,但该酶对10 mg/L CY的降解酶活力仅为1.32 IU/mL[14]。本研究拟将该酯酶基因克隆至载体pESC-HIS上,并转化至食品级感受态细胞酿酒酵母INVSc1中异源表达,通过缺陷型平板SD-H筛选阳性克隆子,诱导表达并纯化后利用SDS-PAGE电泳确定该酶分子质量。以10 mg/L CY为底物,探究其最适降解温度和最佳降解时间,再通过单因素及响应面优化其诱导表达条件,为农药降解适冷酶的工业化生产及酶学特性研究提供材料。
1 材料与方法
1.1 材料与试剂
1.1.1 菌株与质粒
具有降解拟除虫菊酯能力的枯草芽孢杆菌(Bacillus.subtilis)J6,专利保藏,保藏号为CGMCC No.26229;大肠杆菌(Escherichia coli)DH5α,天根生化科技有限公司;克隆载体pMD18-T Vector,宝生物工程(大连)有限公司;pESC-HIS,生工生物工程(上海)股份公司;INVSc1酵母感受态细胞及化学转化试剂盒,上海唯地生物公司。
1.1.2 主要培养基与试剂配制
LB培养基、YPD培养基、不含组氨酸的合成限定培养基(SD-H)、不含组氨酸的合成葡萄糖液体培养基(SGR-H),相应固体培养基添加2%(体积分数)琼脂。蛋白Marker、Ni-IDA 6FF His标签蛋白纯化试剂盒、洗脱液,生工生物工程(上海)股份公司;质粒小提试剂盒,天根生化科技有限公司;酵母质粒提取试剂盒,北京索莱宝科技有限公司;SDS-PAGE凝胶配制试剂盒,上海碧云天生物技术有限公司。
1.2 仪器与设备
TE412-L精密电子天平,北京赛多利斯仪器系统有限公司;LDZX-40AI立式自动电热压力蒸汽灭菌锅,上海三申医疗核子仪器厂;DHG-9162电热恒温培养箱,上海一恒科技有限公司;EDC-810 PCR仪,美国Bio-RAD公司;J92-IIDN超声波细胞粉碎机,宁波新芝生物科技股份有限公司;LC3100高效液相色谱仪,安徽皖仪科技股份有限公司;Gel Doc XR凝胶成像仪,美国伯乐公司;PHSJ3F型pH计,上海仪电科学仪器股份有限公司。
1.3 实验方法
1.3.1 重组质粒的构建
从本实验室前期获得的一株具有降解拟除虫菊酯能力的B.subtilis J6中,提取其基因组DNA,根据目的基因设计特异性引物(表1),进行目的片段的扩增和回收,与pMD18-T载体连接,转化至E.coli DH5α,筛选阳性克隆子,用质粒小提试剂盒提取E.coli DH5α中含有est13基因的质粒,将其作为PCR反应中的模板,以加酶切位点的引物F/R进行PCR扩增,获得含酶切位点目的基因片段est13。将目的基因与pESC-HIS表达载体用EcoR I和Not I限制性内切酶双酶切,连接,利用琼脂糖凝胶电泳鉴定。
表1 PCR引物设计
Table 1 PCR primer design

引物引物序列(5′→3′)est13-FCTAGCTAGCATGAAAATTGTGACACCAAAACCATest13-RCCGCTCGAGCCAATCGAGTTTCTCTAAAAATTCGTAC
1.3.2 阳性克隆子筛选与验证
将构建好的重组质粒pESC-HIS-est13转化至感受态细胞INVSc1中,按照上海唯地生物转化试剂盒操作说明书进行化学转化。随机挑取SD-H板中的阳性克隆子活化后,进行产物测序验证和PCR扩增,将验证正确的pESC-HIS-est13/INVSc1重组菌甘油保藏。
1.3.3 重组酯酶Est13的诱导表达
重组基因工程菌按1%(体积分数)接种于含有2%(体积分数)葡萄糖的100 mL SD-H液体培养基中30 ℃、220 r/min振荡培养24 h。将上述发酵液5 000×g,4 ℃离心15 min,去上清液,PBS离心洗涤一次后,重悬至等体积的SGR-H培养基中,并向上述重悬培养物中加入过膜除菌后的1%(体积分数)棉子糖和2%(体积分数)半乳糖,30 ℃、220 r/min振荡诱导24 h。
1.3.4 重组酯酶Est13的分离纯化
诱导结束后离心(5 000×g、4 ℃、15 min)收集菌体,用适量PBS(pH 7.0)缓冲液洗涤并重悬菌体至原发酵液体积的1/10,使用超声波细胞破碎仪冰浴破碎菌体30 min,离心收集上层清液,即为粗酶液,贮存于4 ℃备用。
使用5 mL Ni-IDA琼脂糖纯化树脂,具体步骤参照Sangon Biotech试剂盒说明书。纯化后的酶液装进透析袋中(截留分子质量8 000~14 000 Da),浸没在0.02 mol/L Tris-HCl (pH 7.0)缓冲液中并在4 ℃下进行透析,透析24 h以上,每2 h更换一次透析液,透析后的蛋白进行SDS-PAGE检测。
1.3.5 重组酯酶Est13对氯氰菊酯的降解验证
以氯氰菊酯为底物,通过检测反应体系中CY的降解率计算酯酶活力。反应体系为3 mL,即在2.4 mL PBS (pH 7.0)缓冲液中,加入0.1 mL 氯氰菊酯-丙酮工作液(0.3 mg/mL),混匀后加入0.5 mL酶液。反应结束后立即加入3 mL乙腈,功率60 W,超声30 min,混匀取1.6 mL离心(12 000 r/min,10 min),取上清液过0.22 μm有机滤膜,使用HPLC对样品中的CY含量进行检测。检测条件:流动相V(乙腈)∶V(水)=83∶17,流速1.0 mL/min,柱温25 ℃,检测波长210 nm,进样量10 μL。对CY的降解率按公式(1)计算:
降解率![]()
(1)
式中:C0为0 h时CY质量浓度,mg/L;Ct为取样时CY残留质量浓度,mg/L。
将上述反应体系分别置于0、4、10、15、20、25、30、37、45 ℃恒温振荡培养箱中振荡4 h,样品经HPLC检测,以体系中最高酶活力为100%计算相对酶活力,确定最适反应温度。再将上述反应体系置于最适温度的恒温振荡培养箱中分别振荡反应10、30、60、90、120、150 min。样品经HPLC检测,以体系中最高酶活力为100%计算相对酶活力,确定最适反应时间。
1.3.6 蛋白浓度测定
采用BCA法测定纯化后的蛋白浓度,操作步骤按照说明书进行。酶活力单位定义:在最适条件下,将每分钟水解1 nmol CY所需要的酶量定义为一个酶活力单位(IU)。
1.3.7 重组酯酶Est13的诱导表达条件优化单因素试验
在1.3.3节的基础下,采用单因素设计法依次考察葡萄糖添加量(0.5%、1%、1.5%、2%、3%、5%,体积分数)、装液量(5%、10%、15%、20%、25%、30%,体积分数)、转速(0、50、100、160、220、250 r/min)、OD600值(0.4、0.6、0.8、1.0、1.2、1.4)、接种量(0.5%、1%、1.5%、2%、2.5%)、诱导温度(20、25、30、35、40 ℃)、半乳糖添加量(1%、1.5%、2%、2.5%、3%,体积分数)及诱导时间(6、12、24、36、48 h)对重组酯酶Est13诱导表达的影响,以诱导结束后,工程菌所产重组酯酶对CY降解的相对酶活力为评价标准,得出最佳诱导表达条件。
1.3.8 重组酯酶Est13的诱导表达条件优化Box-Behnken响应面试验
根据单因素试验结果,以诱导温度(A)、装液量(B)、诱导时间(C)为自变量,以未经优化所产重组酯酶Est13在1.3.5节条件下对10 mg/L氯氰菊酯降解酶活力为100%计算相对酶活力(Y)作为响应值,采用Dedign-Expert 8.0软件设计3因素3水平的Box-Behnken响应面试验。
1.4 数据处理
每组实验设3个平行,结果用“平均值±标准差”表示。采用SPSS 26.0软件对结果进行单因素ANOVA方差分析,采用Design-Expert 10.0.1软件进行响应面设计及分析,采用Origin 2022作图。
2 结果与分析
2.1 酶切鉴定质粒
将构建好的重组质粒使用EcoR I和Not I限制性内切酶双酶切,琼脂糖凝胶电泳结果如图1所示。第1泳道重组质粒出现双条带属于正常情况,因为质粒存在超螺旋、环状、多聚体等形态会导致电泳结果出现多带现象。在第2泳道明显地有2条条带,大小分别为6 700 bp和770 bp左右,与载体大小6 706 bp和基因大小774 bp接近,表达载体和基因大小正确可表明基因est13成功被克隆到载体pESC-HIS中。

M-100~100 00 bp;1-重组质粒pESC-HIS-est13;2-EcoR I/Not I双酶切。
图1 酶切验证重组质粒pESC-HIS-est13
Fig.1 Enzyme digestion validation of recombinant plasmid pESC HIS-est13
2.2 阳性克隆子的筛选
将1.3.2节所述含重组转化子的菌悬液均匀涂布在缺陷型平板SD-H上,30 ℃静置培养3 d后在平板上可见如图2所示的乳白色、有光泽、大小均一的圆形单菌落。随机挑选单菌落至YPD液体培养基30 ℃,160 r/min振荡培养24 h,提取质粒,经PCR扩增验证如图3所示,大小与目的基因大小接近,又经测序验证与参考序列一致,说明重组基因工程菌INVSc1-pESC-HIS-est13构建成功。
图2 重组酿酒酵母INVSc1-pESC-HIS-est13阳性克隆子筛选
Fig.2 Screening of positive clones of recombinant Saccharomyces cerevisiae INVSc1-pESC-HIS-est13

M-100~100 00 bp;1-基因est13;2-空载INVSc1。
图3 重组酿酒酵母INVSc1-pESC-HIS-est13 PCR扩增验证
Fig.3 PCR amplification of recombinant S.cerevisiae INVSc1-pESC-HIS-est13
2.3 重组酯酶Est13的表达与纯化
将构建成功的重组菌INVSc1-pESC-HIS-est13经半乳糖诱导24 h,收集细胞破碎、离心后得到的上清液用于纯化和SDS-PAGE检测。其中取首次纯化得到的纯化酶1 mL再次过镍柱纯化得10 mL纯化酶,即稀释10倍的重组酶。结果如图4所示,重组酯酶Est13经Ni-IDA琼脂糖纯化树脂纯化后得到单一清晰的条带,且粗酶和纯化酶的主条带大小均约28 kDa,与前期预测的分子质量28.331 kDa大小相当。

M-15~130 kDa;1-重组Est13纯化酶;2-稀释10倍的重组Est13纯化酶;3-重组Est13粗酶。
图4 重组酯酶Est13电泳图
Fig.4 Recombinant esterase Est13 electropherogram
2.4 重组酶Est13最适反应温度与反应时间
重组酯酶Est13在不同温度下相对酶活力如图5-A所示,在0~25 ℃酶活力显著升高,25~45 ℃显著下降,且降解温度为25 ℃时,其酶活力显著大于其他温度(P<0.05),所以该重组酶最适降解温度为25 ℃。

A-反应温度;B-反应时间
图5 重组酶Est13最适反应温度与反应时间
Fig.5 Optimal reaction temperature and reaction time of reconstituted enzyme Est13
注:图中不同字母表示处理组之间差异显著(P<0.05)(下同)。
重组酯酶Est13在25 ℃下反应不同时间的相对酶活力如图5-B所示,结果表明,在10~120 min内,相对酶活力显著升高(P<0.05),而大于120 min时无显著变化(P>0.05),故在120 min时已达最佳效果。
重组酯酶对CY降解能力验证表明,纯化后的Est13对10 mg/L的CY降解率为43.287%,蛋白质量浓度为391.428 μg/mL,根据1.3.6节酶活力定义,经计算后得到重组酶的酶活力为17.26 IU/mL。
2.5 优化的重组酯酶Est13诱导表达条件
2.5.1 诱导条件对重组酯酶Est13诱导表达影响
如图6-A所示,重组酯酶Est13对氯氰菊酯的降解酶活力随着葡萄糖添加量升高呈先升后降趋势,少量葡萄糖无法为菌体生长繁殖提供足够能量,而较高葡萄糖会激活酵母自身存在的葡萄糖阻遏效应[21]。只有当培养基中葡萄糖被消耗殆尽时,才能对半乳糖等替代碳源进行利用,酯酶est13基因才能通过半乳糖诱导进行表达。当葡萄糖添加量为0.5%时,其相对酶活力显著高于其他添加量,所以0.5%为可供重组菌生长繁殖但又不会抑制替代碳源利用影响重组酶表达的最佳添加量。

A-葡萄糖添加量;B-装液量;C-转速;D-菌液浓度;E-接种量;F-诱导温度;G-半乳糖添加量;H-诱导时间
图6 诱导条件对重组酯酶Est13诱导表达影响
Fig.6 Effect of induction conditions on the induced expression of recombinant esterase Est13
酵母在诱导表达过程中,换气对重组酶表达也存在影响,适宜的装液量能够提升重组菌的表达效果。如图6-B所示,在使用500 mL的三角瓶进行诱导,装液量为摇瓶体积的5%~20%时,酶活力显著升高(P<0.05),20%~30%时,酶活力显著下降(P<0.05),这可能是由于较少的装液量能溶入更多氧气,使酵母代谢加快,促进目的产物表达。但5%的发酵液体积过小,代谢过快使pH波动较大[22],pH值可通过影响菌体的生长量和细胞膜的通透性来影响酶的产量,进而不利于重组酶表达;而较多的装液量无法提供足够的换气空间,因此最佳装液量为20%。
转速在重组菌诱导表达过程中会直接影响发酵液的换气效果,间接对重组酶的表达产生影响。由图6-C可知,在0~220 r/min内,氯氰菊酯的降解酶活力显著升高(P<0.05),在220~250 r/min内,降解酶活力显著下降(P<0.05)。随着转速增加,液-气相间的传质过程加速,对菌体的生长发育和产物的表达有利[23],所以220 r/min溶氧量最好,为该重组菌诱导表达的最适宜转速。
在诱导前充分活化菌体有助于提高重组菌活力[24],但培养时间过长则会使较多菌体进入诱导时所处周期已过对数期,甚至接近衰亡期,间接降低了重组酶表达效率。如图6-D所示,OD600值0.4~0.8差异不显著,但酶活力显著高于其他菌液浓度(P<0.05),因此诱导前控制OD600值在0.4~0.8即可。
提高接种量能在有限的营养条件下最大程度地发挥重组菌的表达量,但密度过高可能会出现产物抑制、加剧细胞间的竞争和菌体老化等问题造成诱导表达过程不稳定[25]。如图6-E所示,0.5%~1%接种量时,氯氰菊酯降解酶活力无显著差异(P>0.05),1%~2.5%接种量时,氯氰菊酯降解酶活力呈下降趋势,差异显著(P<0.05),所以接种量为0.5%~1%时效果最佳。
诱导温度是影响重组蛋白表达的关键因素之一,低温可以减少副产物生成,可能更有利于目的蛋白的表达,中温是酿酒酵母生长繁殖最适宜的温度范围,但高温会使暴露在该环境下的重组菌分配更多能量应对热应激而影响目的蛋白的表达[26]。由图6-F可知,诱导温度为30 ℃时,酶活力显著高于其他温度(P<0.05),低温并未提高蛋白表达,高温则呈现抑制趋势,所以30 ℃为最佳诱导温度。
重组菌具有pGAL诱导型启动子,诱导表达阶段需要利用半乳糖对其进行诱导[27],目的蛋白的表达情况与诱导剂添加量有关。结果如图6-G所示,1%~2%半乳糖添加量酶活力显著上升(P<0.05),但2%~3%添加量的酶活力无显著差异(P>0.05),从节约成本的角度考虑,选择2%半乳糖添加量即可。
如图6-H所示,6~12 h酶活力显著升高(P<0.05),12~48 h酶活力显著下降(P<0.05),说明该重组菌12 h即可达到最高蛋白表达,无需诱导24 h即缩短人工时间,因此最佳诱导时间可选为12 h。这可能是由于过长时间的诱导会使表达出来的目的蛋白被水解消化[28]。
2.5.2 Box-Behnken设计与结果
通过以上单因素试验结果,选取对重组酿酒酵母工程菌产酯酶Est13的诱导条件有显著影响的3个因素:诱导温度(A)、装液量(B)及诱导时间(C)为自变量,以未经优化所产重组酯酶Est13在1.3.5节条件下对10 mg/L氯氰菊酯降解酶活力为100%计算相对酶活力为响应值(Y),采用 Design Expert 10.0.1中心组合法设计了17组试验方案,进行响应面分析,试验设计方案和结果如表2所示。
表2 Box-Behnken试验设计及结果
Table 2 Box-Behnken experimental design and results

编号诱导温度/℃装液量/%诱导时间/h相对酶活力/%125151257.609235151266.340325251264.840435251243.29952520657.59463520644.077725201873.037835201867.79493015677.091103025673.76611301518107.9971230251895.26713302012120.98914302012121.85015302012122.16016302012119.54617302012119.559
使用Design Expert 10.0.1软件对表2数据进行多元回归拟合,得到诱导温度(A)、装液量(B)、诱导时间(C)之间的多项回归方程为:Y=-869.758 35+49.03651A+16.077 36B+4.892 60C-0.131 04AB+0.029 846AC-0.033 932BC-0.785 26A2-0.302 09B2-0.178 48C2。
2.5.3 回归模型的建立及显著性检验
根据上述实验数据及回归方程,对回归模型的显著性分析结果如表3所示。
表3 回归模型的显著性分析结果
Table 3 Significance analysis results of the regression model

方差来源平方和自由度均方F值P值显著性模型2 494.449277.16318.94<0.000 1∗∗A-诱导温度23.34123.3426.860.001 3∗B-装液量23.78123.7827.370.001 2∗C-诱导时间196.381196.38225.99<0.000 1∗∗AB42.93142.9349.400.000 2∗AC3.2113.213.690.096 2BC4.1414.144.770.065 3A21 622.7111 622.711867.33<0.000 1∗∗B2240.161240.16276.36<0.000 1∗∗C2173.831173.83200.04<0.000 1∗∗残差6.0870.87失拟项4.9431.655.770.061 8纯误差1.1440.29总和2 500.5216R2=0.997 6R2Adj=0.994 4
注:**表示结果差异极显著(P<0.001);*表示结果差异显著(P<0.01)。
由表3结果可知,回归模型极显著(P<0.001),失拟项不显著(P>0.05),表明该模型优化的因素设计合理。由回归方程系数显著性检验可知:模型中一次项A、B、C均显著(P<0.01),二次项A2、B2、C2均显著;交互项AB显著,AC和BC均不显著(P>0.05),各因素的F值对实验结果的影响排序为C>B>A,即3个因素对诱导产酯酶Est13的影响大小为诱导时间>装液量>诱导温度。该模型的因变量与自变量之间的线性关系R2=0.997 6,校正系数![]() 说明实测相对酶活力与模型预测值之间的的拟合度良好,因此该模型可用于分析和预测重组酯酶Est13酶活力的最佳诱导表达条件。
说明实测相对酶活力与模型预测值之间的的拟合度良好,因此该模型可用于分析和预测重组酯酶Est13酶活力的最佳诱导表达条件。
2.5.4 交互作用分析
根据二次响应面回归方程,在Design Expert 10.0.1中绘制响应面交互作用图,对重组基因工程菌产酯酶Est13诱导条件影响显著的各两因素的交互作用拟合的等高线和响应曲面如图7所示。

A、C、E-三维响应面图;B、D、F-二维等高线图
图7 不同因素间交互作用对重组酯酶Est13诱导表达影响的响应面及等高线
Fig.7 The response surface and contour of the interaction between different factors on the induced expression of recombinant esterase Est13
等高线直观反映了不同因素交互作用的强弱,所以由图7可知,立体抛物面开口向下,存在极大值。诱导温度和装液量的曲线均表现陡峭,对响应值影响较大,诱导时间则表现为圆平曲线,因此对响应值影响较小。根据软件分析结果,重组酿酒酵母工程菌在最优诱导条件为诱导温度30.020 ℃、装液量18.125%、诱导时间14.052 h下,所产酯酶Est13预估2 h对10 mg/L的氯氰菊酯降解的相对酶活力为122.338%。
2.5.5 回归模型的验证
根据上述回归模型可得到最优表达条件,为进一步确定重组菌株产酯酶Est13的最优诱导条件,需对响应面优化工艺进行验证。考虑实际的操作情况,调整预测条件为诱导温度30 ℃、装液量18%、诱导时间14 h,重复3次实验,重组酯酶Est13 2 h对10 mg/L的氯氰菊酯降解的相对酶活力平均值为123.145%,酶活力为21.34 IU/mL,与模型预估值相符,说明响应面优化酯酶Est13的诱导表达条件是可靠的。
3 结论与讨论
酶降解是当今公认的“绿色”技术,目前已有大量PYRs水解酯酶被报道且部分采用大肠杆菌进行了表征[9-10,12,14-15,29-31],其中多数为催化温度在35~80 ℃的中高温酶。相较于中高温酶,同类型的适冷酶在食品加工及清洗减除果蔬农残中更具优势和应用价值[32],特别是对于一些生吃的果蔬,中高水温不利于保持果蔬品质。因此本实验室前期利用大肠杆菌E.coli BL21(DE3)表征的酯酶Est13经验证为适冷酶,但纯化后对CY的降解酶活力仅为1.32 IU/mL[14],同时大肠杆菌属于致病菌[33],其在食品、饲料等行业的应用存在极大的安全隐患[34],且大多数报道仍停留在表征和酶学性质的研究上,应用研究极少。为了能最大限度地应用于食品工业,本文选择了从宿主、载体到诱导剂均为食品级的酿酒酵母表达系统[20]。李蓬茸等[35]将α-淀粉酶基因成功克隆表达到酿酒酵母中,生产出安全无毒害的α-淀粉酶用于食品制作,重组菌表达α-淀粉酶最大产酶浓度为2 809.1 U/mL。而本文构建的酿酒酵母工程菌INVSc1-pESC-HIS-est13表征并纯化的适冷酯酶Est13的降解酶活力为21.34 IU/mL,较在大肠杆菌中表达有显著提高。对于胞内酶,微生物会通过自身细胞结构吸附农药,使农药进入细胞内,再通过自身关键酶特异性地切断酯键把农药降解。但仅有少量野生型酵母菌吸附脱除CY的报道,酵母源酯降解酶的研究鲜有报道。ZHANG等[36]利用酿酒酵母YS81细胞壁吸附作用,0.25 h对CY的脱除率为55.06%。这可能是由于酵母菌细胞壁的“三明治”结构较厚,其主要成分甘露聚糖可以控制细胞壁孔径并通过分子间作用力牢牢吸附并阻止有毒有害物质进入细胞内[37]。因此本研究相较于课题组前期在大肠杆菌中进行异源表达而言,将源于枯草芽孢杆菌J6的氯氰菊酯降解酶基因est13在酿酒酵母INVSc1中进行异源表达,不仅为食品级宿主菌表征PYRs降解酶用于农产品领域提供新思路,也为酵母菌表达酯酶及降解PYRs机制研究提供了参考依据。
在本研究中,重组基因工程菌INVSc1-pESC-HIS-est13实现了重组酯酶Est13稳定表达,同时通过采用单因素试验和响应面试验优化了其诱导表达条件。结果表明,酿酒酵母基因工程菌INVSc1-pESC-HIS-est13所分泌的重组酯酶对10 mg/L的氯氰菊酯降解的相对酶活力提高为123.145%,酶活力提高为21.34 IU/mL,优化效果显著。生产出的重组酯酶安全、绿色、无毒害,为后续将适冷酯酶应用于研发果蔬清洗酶制剂实验研究奠定了理论基础。
[1] 周亮成,李运,李卓苗,等.枯草芽孢杆菌BSF01菌剂制备及对高效氯氰菊酯的降解效果[J].华南农业大学学报,2018,39(3):54-59.ZHOU L C,LI Y,LI Z M,et al.Preparation of bacterial agent based on Bacillus subtilis BSF01 and its biodegradation effect on beta-cypermethrin[J].Journal of South China Agricultural University,2018,39(3):54-59.
[2] SPARKS T C,NAUEN R.IRAC:Mode of action classification and insecticide resistance management[J].Pesticide Biochemistry and Physiology,2015,121:122-128.
[3] WANG R,ZHANG S W,XIAO K Y,et al.Occurrence,sources,and risk assessment of pyrethroid insecticides in surface water and tap water from Taihu Lake,China[J].Journal of Environmental Management,2023,325:116565.
[4] ZHANG Q,YING Z T,TANG T,et al.Residual characteristics and potential integrated risk assessment of synthetic pyrethroids in leafy vegetables from Zhejiang in China-Based on a 3-year investigation[J].Food Chemistry,2021,365:130389.
[5] 张贤辉,余旻昊,胡广军,等.淮南市叶菜类蔬菜中拟除虫菊酯农药残留及膳食暴露风险分析[J].安徽农业科学,2020,48(20):192-194.Journal of Anhui Agricultural Sciences,2020,48(20):192-194.ZHANG X H,YU M H,HU G J,et al.Analysis of pyrethroid pesticide residues and dietary exposure risk in leafy vegetables in huainan city[J].Journal of Anhui Agricultural Sciences,2020,48(20):192-194.
[6] 陈湘艺,李小玲,黄华伟,等.气相色谱法测定养殖水体及水产品组织中的拟除虫菊酯[J].安徽农业科学,2015,43(14):96-98; 114.CHEN X Y,LI X L,HUANG H W,et al.Determination of pyrethroids residues in cultural water and aquatic product tissues by gas chromatography[J].Journal of Anhui Agricultural Sciences,2015,43(14):96-98; 114.
[7] ZHAN H,HUANG Y H,LIN Z Q,et al.New insights into the microbial degradation and catalytic mechanism of synthetic pyrethroids[J].Environmental Research,2020,182:109138.
[8] 谷欣悦,李琴,张依婷,等.微生物对拟除虫菊酯类农药吸附和降解机制研究进展[J].食品科学,2024,45(19):342-352.GU X Y,LI Q,ZHANG Y T,et al.Research progress in the mechanisms of microbial adsorption and degradation of pyrethroids pesticides[J].Food Science,2024,45(19):342-352.
[9] XIAO Y,LU Q Q,YI X,et al.Synergistic degradation of pyrethroids by the quorum sensing-regulated carboxylesterase of Bacillus subtilis BSF01[J].Frontiers in Bioengineering and Biotechnology,2020,8:889.
[10] LIU Y,TANG S K,WANG X,et al.A novel thermostable and salt-tolerant carboxylesterase involved in the initial aerobic degradation pathway for pyrethroids in Glycomyces salinus[J].Journal of Hazardous Materials,2023,451:131128.
[11] DING J M,LIU Y,GAO Y X,et al.Biodegradation of λ-cyhalothrin through cell surface display of bacterial carboxylesterase[J].Chemosphere,2022,289:133130.
[12] FAN X J,ZHAO M,WEN H M,et al.Enhancement degradation efficiency of pyrethroid-degrading esterase (Est816) through rational design and its application in bioremediation[J].Chemosphere,2023,319:138021.
[13] FAN X J,LIANG W Q,LI Y F,et al.Identification and immobilization of a novel cold-adapted esterase,and its potential for bioremediation of pyrethroid-contaminated vegetables[J].Microbial Cell Factories,2017,16(1):149.
[14] ZHANG M M,YANG K,YANG L,et al.A novel cold-adapted pyrethroid-degrading esterase from Bacillus subtilis J6 and its application for pyrethroid-residual alleviation in food matrix[J].Journal of Hazardous Materials,2024,463:132847.
[15] CAI X H,WANG W,LIN L,et al.Autotransporter domain-dependent enzymatic analysis of a novel extremely thermostable carboxylesterase with high biodegradability towards pyrethroid pesticides[J].Scientific Reports,2017,7:3461.
[16] KURODA K,ARAI Y,REZAEI N,et al.Devil’s staircase transition of the electronic structures in CeSb[J].Nature Communications,2020,11:2888.
[17] 冀成法,刘忠,马鲁南,等.重组大肠杆菌高密度、高表达研究进展[J].生物技术,2022,32(2):246-251.JI C F,LIU Z,MA L N,et al.Review of high density fermentation and high expression of engineering E.coli[J].Biotechnology,2022,32(2):246-251.
[18] 李艳,王正祥,诸葛健.酵母作为外源基因表达系统的研究进展[J].生物工程进展,2001,21(2):10-14.LI Y,WANG Z X,ZHUGE J.Advances in the studies of yeast as foreign genes expression system[J].Progress in Biotechnology,2001,21(2):10-14.
[19] LIU J,YAN D Z,ZHAO S J.Expression of monellin in a food-grade delivery system in Saccharomyces cerevisiae[J].Journal of the Science of Food and Agriculture,2015,95(13):2646-2651.
[20] 梁琰.嗜热链球菌中基于乳糖代谢的食品级表达系统构建与应用[D].济南:齐鲁工业大学,2022.LIANG T.Construction and application of a food-grade expression system based on lactose metabolism in Streptococcus thermophilus[D].Jinan:Qilu University of Technology,2022.
[21] 吴迪,程艺超,姜娇,等.酵母中葡萄糖阻遏作用机制研究进展[J].微生物学报,2023,63(9):3409-3427.WU D,CHENG Y C,JIANG J,et al.Mechanism of glucose repression in yeast Mechanism of glucose repression in yeast[J].Acta Microbiologica Sinica,2023,63(9):3409-3427.
[22] 潘冬梅,杨传伦,张心青,等.酿酒酵母培养条件优化[J].中国饲料,2024(6):9-13.PAN D M,YANG C L,ZHANG X Q,et al.Optimization of culture conditions of Saccharomyces cerevisiae[J].China Feed,2024(6):9-13.
[23] 兰雪.高产木聚糖酶酿酒酵母工程菌的构建及发酵条件优化[D].长春:吉林农业大学,2018.LAN X.Construction of High-yield Xylanase Saccharomyces cerevisiae Engineering Bacteria and Optimization of Fermentation Conditions[D].Changchun:Jilin Agricultural University,2018.
[24] 夏瑛,李良,董孝元,等.源于解淀粉芽胞杆菌酚酸脱羧酶的克隆与表达[J].微生物学通报,2020,47(7):2060-2071.XIA Y,LI L,DONG X Y,et al.Cloning and expression of phenolic acid decarboxylase from Bacillus amyloliquefaciens[J].Microbiology China,2020,47(7):2060-2071.
[25] 刘锋.酿酒酵母高密度发酵技术分析[J].食品安全导刊,2024(19):168-171.LIU F.Analysis of High-density fermentation technology of Saccharomyces cerevisiae[J].China Food Safety Magazine,2024 (19):168-171.
[26] 陶康.产芳樟醇重组酿酒酵母发酵工艺优化及中试放大研究[D].北京:北京化工大学,2024.TAO K.Optimization of fermentation process of linalool producing recombinant saccharomyces cerevisiae and pilot scale study[D].Beijing:Beijing University of Chemical Technology,2024.
[27] 蒋慧慧,王强,饶志明,等.酿酒酵母启动子工程研究进展[J].中国生物工程杂志,2023,43(11):78-91.JIANG H H,WANG Q,RAO Z M,et al.Research progress of the promoter engineering in saccharomyces cerevisiae[J].China Biotechnology,2023,43(11):78-91.
[28] FARSIANI H,MOSAVAT A,SOLEIMANPOUR S,et al.Fc-based delivery system enhances immunogenicity of a tuberculosis subunit vaccine candidate consisting of the ESAT-6:CFP-10 complex[J].Molecular BioSystems,2016,12(7):2189-2201.
[29] LUO X W,ZHANG D Y,ZHOU X G,et al.Cloning and characterization of a pyrethroid pesticide decomposing esterase gene,Est3385,from Rhodopseudomonas palustris PSB-S[J].Scientific Reports,2018,8:7384.
[30] HU W,LU Q Q,ZHONG G H,et al.Biodegradation of pyrethroids by a hydrolyzing carboxylesterase EstA from Bacillus cereus BCC01[J].Applied Sciences,2019,9(3):477.
[31] XU D Q,GAO Y Y,SUN B,et al.Pyrethroid carboxylesterase PytH from Sphingobium faniae JZ-2:Structure and catalytic mechanism[J].Applied and Environmental Microbiology,2020,86(12):e02971-19.
[32] 吴继卫.适冷酶及其适冷机制[J].安徽农业科学,2011,39(23):13938-13939;13941.WU J W.Cold-adapted enzymes and their cold-adapted mechanism[J].Journal of Anhui Agricultural Sciences,2011,39(23):13938-13939; 13941.
[33] FOPPEN J A,SCHIJVEN J F.Evaluation of data from the literature on the transport and survival of Escherichia coli and thermotolerant coliforms in aquifers under saturated conditions[J].Water Research,2006,40(3):401-426.
[34] 胡慧.大肠杆菌在多介质中分布及迁移的试验研究[D].焦作:河南理工大学,2022.HU H.Experimental study on the distribution and migration of Escherichia coli in multi-media[D].Jiaozuo:Henan Polytechnic University,2022.
[35] 李蓬茸,曾维斯,彭芳,等.蜜蜂α-淀粉酶基因在酿酒酵母中的表达[J].武汉轻工大学学报,2022,41(6):53-59.LI P R,ZENG W S,PENG F,et al.Expression of a-amylase gene from Apis mellifera L.in Saccharomyces cerevisiae[J].Journal of Wuhan Polytechnic University,2022,41(6):53-59.
[36] ZHANG M M,WEN Y L,LUO X L,et al.Characterization,mechanism of cypermethrin biosorption by Saccharomyces cerevisiae strains YS81 and HP and removal of cypermethrin from apple and cucumber juices by inactive cells[J].Journal of Hazardous Materials,2021,407:124350.
[37] 廖灿青,周小辉,徐云强,等.酵母细胞壁来源、作用机理及在动物养殖中的应用[J].中国饲料,2024(7):168-172.LIAO C Q,ZHOU X H,XU Y Q,et al.Origin,mechanism and application of yeast cell wall in animal culture[J].China Feed,2024(7):168-172.